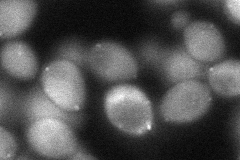
YGL037C

View description
Nicotinamidase that converts nicotinamide to nicotinic acid as part of the NAD(+) salvage pathway, required for life span extension by calorie restriction; PNC1 expression responds to all known stimuli that extend replicative life span
Localization:
Intensity:
Fold change:
Significance:
-
C’ GFP library in SD

punctate143.77 -
N' NOP1pr-GFP in SD

punctate177.532 -
N' TEF2pr-mCherry in SD

cytosol327.639 -
N' NATIVEpr-GFP in SD

punctate169.61 -
N' TEF2pr-VC and Cyto-VN in SD
cytosol,punctate66.7083 -
C’ GFP library in SD+DTT

punctate288.852Yes -
C’ GFP library in SD+H2O2

punctate128.570.89No -
C’ GFP library in Starvation Media

punctate502.873.49Yes -
C’ GFP library on the background of Pup2-DaMP

punctate -
C’ GFP library on the background of CCT mutant

punctate178.5651.24197No
